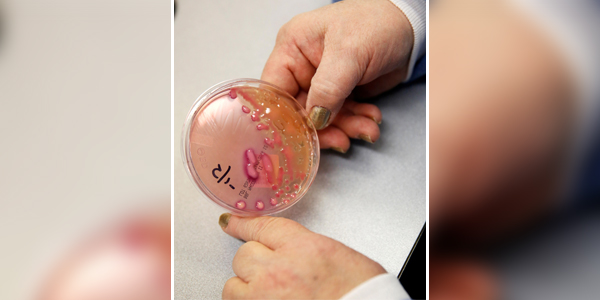
No Image

الالتهاب الرئوي يقتل طفلا كل 39 ثانية
قالت وكالات صحية عالمية، اليوم الثلاثاء، إن الالتهاب الرئوي يقتل طفلا كل 39 ثانية أو قتل ما يربو على 800 ألف طفل العام الماضي رغم إمكانية الشفاء والوقاية منه في الغالب.
وفي تقرير حول ما وصفوه بأنه «الوباء المنسي»، حثت منظمة الأمم المتحدة للطفولة (اليونيسف) ومنظمة إنقاذ الطفولة الخيرية وأربع وكالات صحية أخرى الحكومات على زيادة الاستثمار في اللقاحات للوقاية من المرض وفي الخدمات الصحية والأدوية لعلاجه.
وقال سيث بيركلي، الرئيس التنفيذي لتحالف جافي للقاحات «حقيقة أن هذا المرض الذي يمكن الوقاية منه وعلاجه وتشخيصه بسهولة لا يزال أكبر قاتل للأطفال الصغار في العالم تبعث على الصدمة».
والالتهاب الرئوي أحد أمراض الرئة الناجمة عن البكتيريا أو الفيروسات أو الفطريات.


